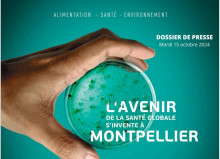
MV 2e assises

Salle de presse
Vous cherchez des informations sur les atouts du territoire montpelliérain ? Vous souhaitez découvrir nos outils de communication ? Consultez notre centre de ressources
Développement Économique : Montpellier Méditerranée Métropole participe à deux salons nationaux et internationaux dédiés à l'innovation, Santexpo Et Vivatech
International et Développement Économique : Montpellier Méditerranée Métropole organise "Cap sur le Québec", un forum économique France - Québec, mardi 2 juin au domaine de Grammont
Satis +, le rendez-vous professionnel dédié à la fabrication des œuvres audiovisuelles revient à Montpellier les 1er et 2 juillet 2026
Agroécologie et Alimentation Durable : Manger comme on sème, le Festival des 4 saisons revient pour une nouvelle édition printemps/été du 22 mai au 7 juin
Quartier Cambacérès à Montpellier : Manuelle Gautrand, architecte d'un nouveau projet emblématique du quartier
Attractivité et Développement Économique : La Plateforme Clause Sociale de la Métropole de Montpellier enregistre un bilan exceptionnel pour l'année 2025
Développement Économique : Le BIC de Montpellier classé dans le top 10 des meilleurs incubateurs de startups en Europe par le magazine "Financial Times"
Développement Économique et Transition Ecologique : Dans le cadre de la dynamique Medvallée, Montpellier Méditerranée Métropole Et ses partenaires participent au "One Health Summit", une nouvelle reconnaissance pour l'écosystème montpelliérain
Cinéma : Le documentaire "Le renard qui a sauvé son île" soutenu par le fonds d'aide à la création ICC au programme du festival du documentaire pour les jeunes qui se tient les 31 janvier et 1er février à la Halle Tropisme
La Ligne 5 de tramway est en service !
La plateforme oÙsoigner.fr - acteur de la lutte contre la désertification médicale
Montpellier Events renouvelle sa certification ISO 20121
Développement Économique et Innovation : Le BIC de Montpellier a organisé la deuxième édition du Startup Day
Industries Culturelles et Créatives : Le jeu montpelliérain "Clair Obscur : expédition 33" sacré aux Game Awards
Pose de la première pierre de la Cité de l’Alimentation. Un projet au service de la restauration collective durable
Le 20 décembre 2025, une journée pour célébrer la ligne 5
Cinéma : Montpellier Méditerranée Métropole soutient le festival l'Illuminé qui se tiendra du 28 au 30 novembre 2025
La 10e édition de Cœur de Ville en Lumières - qui s'est tenue du 13 au 15 novembre - a remporté un franc succès auprès du public
Le festival "Manger comme on sème" revient pour son édition hivernale du 22 novembre jusqu'à 7 décembre 2025
Cykero ouvre son premier pop-up store à Montpellier, 10 place comédie : une vitrine du reconditionné haut de gamme et durable
Commerces : Remise des clés à la nouvelle enseigne danoise "SØSTRENE GRENE" qui s'installe dans l'immeuble le Capoulié rue Maguelone
Agora des Savoirs : présentation du premier cycle de la saison 2025-2026
À Montpellier, l'extension de la ligne 1 de tramway entre en service
Hub International de l'Innovation : lancement d'un projet d'appui à la structuration des écosystèmes d'innovation en Afrique de l'ouest
Conseil de Métropole : Montpellier Méditerranée Métropole a adopté ses nouvelles feuilles de route Vin et Oenotourisme
Hub International de l'Innovation
Présentation de la seconde édition de la Biennale Euro-Africa de Montpellier qui se tiendra du lundi 6 au dimanche 12 octobre inclus
Terratis déploie sa solution innovante à Montpellier
Projection en avant-première du documentaire "Art brut et bêtes sauvages" de Philippe Lespinasse, lundi 8 septembre au cinéma Nestor Burma, un film soutenu par le fonds d'aide à la création ICC
Montpellier Méditerranée mMétropole salue le succès d'Abivax qui a réussi la phase 3 de test de son nouveau médicament destiné à lutter contre certaines maladies chroniques des intestins
Montpellier et l’Occitanie, territoires engagés pour le tourisme durable, accueillent le congrès mondial Green Destinations du 28 au 30 septembre 2025
Montpellier Méditerranée Métropole organise "Cap sur le Maroc", les rencontres économiques Montpellier-Maroc, le mardi 9 septembre à l'opéra comédie
La métropole de Montpellier offre 33 vélos de son parc aux ateliers du lycée professionnel pierre Mendès France
La construction d'une ressourcerie et l'extension de la déchèterie adjacente formeront le futur Pôle Métropolitain d'Économie Circulaire à Grabels
Commerces : La Cagette, premier supermarché coopératif de Montpellier s'agrandit
Inauguration du Pôle Autonomie Santé à Lattes
Le Conseil de Développement de Montpellier Méditerranée Métropole : entre bilan et perspectives
La Métropole de Montpellier, 1er territoire d’Occitanie pour le covoiturage du quotidien en 2024
Attractivité & Développement Économique : Montpellier Méditerranée Métropole a présenté sa feuille de route du Tourisme Durable 2030
Montpellier Méditerranée Métropole a organisé la seconde Matinale des Mécènes du territoire de Montpelier ce jeudi 26 juin 2025
Développement Économique : Montpellier Méditerranée Métropole au rendez-vous des nouvelles technologies, de l'IA et des entreprises innovantes lors du salon Vivatech, retour d'expériences
Commerces : L'enseigne "Antoine et Lili" s'installe au 10 place de la Comédie dès le vendredi 20 juin
Développement Économique : Le BIC de Montpellier lance "Conquête", un tout nouveau parcours destiné à compléter l'offre d'accompagnement proposée aux startups et aux entreprises en développement
Montpellier Sud : un nouveau quartier mixte qui se dévoile peu à peu
Développement Économique : Montpellier Méditerranée Métropole est présente au salon Vivatech à Paris du 11 au 14 juin prochains, une occasion de dévoiler toute la richesse entrepreneuriale de notre territoire en matière d'innovation, de nouvelles technolo
Agroécologie et alimentation durable : Manger comme on sème, le festival des 4 saisons revient pour une nouvelle édition
"Montpellier fait le choix de la culture" : La ville de Montpellier lance, pour la 4e année consécutive, son dispositif d'aide à l'investissement en faveur du développement des activités culturelles et artistiques
La dynamique MedVallée rayonne au national et à l'international avec une présence des équipes montpelliéraines sur trois salons économiques d'envergure
Mise en service de la première ligne de Bustram
Présentation de la nouvelle plateforme Bocal, Un véritable lieu de rencontre entre producteurs, commerçants et habitants du territoire, une vitrine de l'alimentation locale et durable
Montpellier fait le choix de la culture" et lance un fonds d'urgence de soutien au tissu culturel
Développement Économique : Montpellier Méditerranée Métropole accueille "Montpellier in Space", un afterwork exceptionnel consacré au domaine spatial, à la Halle de l'Innovation
Industries Culturelles et Créatives : Le fonds d'aide à la création ICC soutient 37 projets de la filière de l'image lors de la session 2024
MedVallée : Six nouveaux lauréats rejoignent le dispositif Boost Invest MedVallée en ce début d'année 2025
Passage du Tour de France 2025 à Montpellier la ville se prépare à accueillir la 112e édition de la grande boucle - Un tramway habillé aux couleurs du tour de France
Signature d’un partenariat entre le Pôle Universitaire d’Innovation (PUI) de Montpellier et 7 pôles de compétitivité
Trois startups incubées au BIC de Montpellier classées dans le top 100 des startups dans lesquelles il faut investir en 2025 par le magazine Challenges
Tropisme, le quatrième pop-up à s’installer au 10 place de la Comédie
Swing, une application pour faciliter les remplacements médicaux
L'Agence de Développement et des Transitions de Montpellier a organisé le plus grand Hackathon solidaire de France
Succès au sein de MedVallée Montpellier : cinq startups enregistrent des levées de fonds conséquentes
Virginie Guilminot a travaillé sur "Flow", Oscar du meilleur film d’animation
International & MedVallée : signature du nouveau plan consolidé France CGIAR 2026-2028 - Une avancée importante pour Montpellier
Journée mondiale de la santé orale jeudi 20 mars à Montpelier faire de Montpellier un territoire exemplaire et innovant en santé orale
Sanofi lance à Montpellier la tournée de Zeus, le cheval métallique de la cérémonie d'ouverture des JO de Paris 2024
Industries Culturelles et Créatives : Montpellier, territoire de référence du jeu vidéo, se distingue lors de la cérémonie des Pégases 2025
Lancement de l’association IA Montpellier Méditerranée
"Dans les coulisses de la série arcane", une exposition inédite à l'Hôtel de Ville de Montpellier
Vie étudiante : Montpellier reçoit, pour la deuxième année consécutive, le prix de la meilleure ville étudiante par le magazine l'Étudiant
Montpellier Méditerranée Métropole met en place un Comité Métropolitain de l'Intelligence Artificielle et du Numérique
MONTPELLIER, Ville modèle pour les transitions agricoles et alimentaires
La Halle de l'innovation fête ses 1 an d'existence : le BIC organise le Startup Day Montpellier
La fresque hommage à la série Arcane dévoilée au public
Lancement du cluster ENR à Montpellier
MEDVALLÉE DEUXIÈMES ASSISES
Pôle vins de Montpellier Méditerranée Métropole : 11 nouveaux "coups de cœur du vin" attribués aux cuvées de la métropole
l'Agence de Développement et des Transitions lance un partenariat clé avec l'Union des Industries et des Métiers de la Métallurgie (UIMM) Occitanie Méditerranée Ouest
MedVallée : Montpellier lance avec Innov Biotech et Predia le projet inédit "Dinamics"
Premières Rencontres Énergies Renouvelables sur le Territoire de la Métropole
Imaginer et construire le commerce de demain en centre-ville
Lancement de l'Agence de Développement et des Transitions
Écologie de la santé : une convention inédite entre la Ville, la Métropole de Montpellier et les instituts de recherche pour mieux tenir compte des interactions entre biodiversité et santé
Medincell : Succès historique au coeur de MedVallée
Première Biennale Euro-Africa Montpellier
IHU IMMUN4CURE : Un site d’excellence et d’innovation où s’inventera la médecine de demain
Marché d'Intérêt National de Montpellier (MIN)